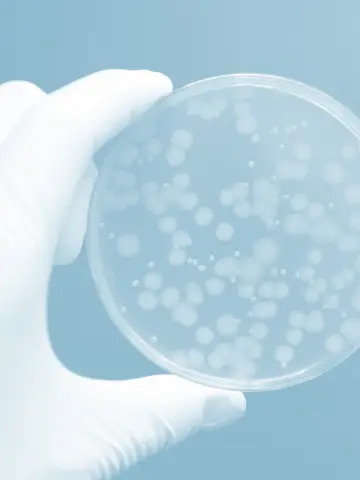
Rozbor vody

otevírací doba do konce roku 2025: v prodejně budeme do 19.12.2025 - budou zpracované objednávky, provedené do 18.12.2025, následující rok jsme v prodejně od 5.1.2026 a budou postupně zpracovávány objednávky došlé od 19.12.2025.

Chcete čistou vodu nejen na pití, ale i na vaření? Víte, že nejlepším řešením je kvalitní vodní filtr, ale nevíte, jaký typ zvolit? Tady je náš stručný návod:

Některé nedostatky Vaší vody poznáte i bez laboratorního rozboru. Pokud je Vaše voda zakalená, máte staré trubky nebo musíte často čistit perlátory vodovodních baterií, je namístě pořídit si mechanický filtr. Ten se v zásadě hodí do každé domácnosti. Usnadní Vám i případnou reklamaci domácích spotřebičů, neboť Vám jejich výrobce nemůže tvrdit, že se poškodily mechanickými nečistotami, tedy Vaší vinou. Montuje se na vstupu do domu (Cintropur, Rainfresh) nebo bytu (Cintropur, Atlas). Pod kuchyňskou linku se používá jako ochrana membrány ultrafiltrace, aby se její jemné póry příliš brzo nezanesly mechanickými nečistotami. S výhodou se používá i pro ostatní typy vodních filtrů.
Obtěžuje Vás nadměrné usazování vodního kamene? Příčinou je vysoká přechodná tvrdost vody, zjednodušeně řečeno máte ve vodě hodně vápníku a hořčíku. Ty jsou ale pro zdraví velmi prospěšné. Známý je slogan „Čím tvrdší voda, tím měkčí aorta“. Je tedy třeba zvážit, zda pořídit filtr na snížení přechodné tvrdosti nebo raději odstraňovat vodní kámen octem. Tento typ filtru je vhodný pouze při extrémně vysoké tvrdosti nebo pokud Vám snížení hodnot vápníku a hořčíku doporučí Váš lékař (např. pro ledvinové kameny). Vhodnou alternativou je nádobový filtr snižující tvrdost, pomocí kterého si upravíte vodu pro čaj nebo kávu, a na pití a vaření použijete průtokový filtr, např. s aktivním uhlím. Pro ochranu spotřebičů doporučujeme zařízení na bázi polyfosfátů: bojlerový změkčovač, pračkový změkčovač (pro pračku i myčku). Hodnotu tvrdosti vody můžete změřit i testačními proužky.


Jestliže bydlíte v blízkosti polí, je pravděpodobné, že se do Vaší studniční vody dostává zvýšené množství dusičnanů. Můžete to ověřit proužky na stanovení dusičnanů. Na odstranění dusičnanů (přestože norma připouští 50 mg/l, doporučená hodnota pro dospělé dle normy je 15 mg/l a koncentrace dusičnanů v nedotčené přírodě se pohybuje okolo 2 mg/l) a snížení dalších škodlivých látek (např. chlor, nachlorované organické látky, těžké kovy, saponáty, herbicidy, pesticidy, hormony, antibiotika) je vhodný vodní filtr s iontovýměnnou pryskyřicí (anexem).
Pokud používáte vodu z vodovodního řadu nebo chlorujete studnu, zařaďte filtr s aktivním uhlím. Tato čistě přírodní hmota, vyráběná za vysokých teplot z kokosových skořápek, dokáže na sebe navázat každou jen trochu složitější molekulu. Z našeho sortimentu obsahuje nejvíc aktivního uhlí Dionela FAM1. Tento filtr výrazně zlepšuje chuť vody a s vysokou účinností odstraňuje širokou škálu škodlivin jako jsou např. chlor, nachlorované organické látky, těžké kovy, saponáty, pesticidy, hormony nebo antibiotika. Jako jediný filtr této kategorie na trhu snižuje i hodnoty arzenu, berylia a antimonu. Do koupelny je vhodný odchlorovací sprchový filtr.

Pokud Vám rezavá studniční voda barví prádlo, je dobré zainvestovat do zařízení na odstranění železa a manganu. Poradíme Vám spolehlivou firmu, která se na tyto filtry specializuje. Vzhledem k tomu, že zachytávání těchto prvků vyžaduje každodenní automatický zpětný proplach filtru, montuje se toto zařízení výhradně na vstupu do domu. Menší zařízení do kuchyně by Vám brzy přestalo fungovat.
Na zjištění dalších kontaminantů už potřebujete rozbor vody z akreditované laboratoře. V případě, že máte vodu z vodovodního řadu, můžete rozbor najít na internetu, kde ho uveřejňují vodárny. U studniční vody je třeba investovat, ale základní rozbor pořídíte za cca 1000 Kč. V něm se dozvíte nejen přesné hodnoty výše zmíněných látek („tvrdost“ (Ca + Mg), dusičnany (NO3-), volný chlor, železo, mangan), ale i případný výskyt bakterií, arzenu a hodnoty CHSKMn nebo pH.

Pokud jsou v rozboru vody zjištěny patogenní bakterie (Escherichia coli, enterokoky, koliformní bakterie apod.), doporučujeme následující postup. Několik let nečištěnou studnu je třeba mechanicky vyčistit a jednorázově přechlorovat. Po čtrnáctidenním provozu nechte udělat nový rozbor vody jen na bakterie. Pokud jsou stále významně zvýšeny, můžete studnu pravidelně dezinfikovat chlorem nebo stříbrem, ale elegantnějším řešením je použít UV lampu na vstupu do domu. Tu doporučujeme zejména rodinám s miminkem, protože při jeho koupání nelze uhlídat, že si nelokne vody. Pokud se nerozhodnete pro UV lampu, je důležité pořídit si alespoň mikrofiltraci nebo ultrafiltraci do kuchyně. Tyto membrány mají porozitu 0,1 µm, resp. 0,01 µm, projdou tedy cenné minerály, nejedná se o reverzní osmózu. Ta i v případě, že je vybavena remineralizační patronou, poskytuje vodu se zanedbatelným množstvím minerálů, nevhodnou k pití.
Máte-li arzen v normě (do 10 µg/l), stačí zvolit filtr s menším množstvím hmot na odstranění arzenu, překračuje-li normu např. v oblastech s břidlicovým nebo žulovým podložím nebo v okolí metalurgických závodů), pořiďte si specializovaný filtr. Arzen opravdu není zdraví prospěšný, proto se ho snažte snížit na minimum.
V případě, že Vaše voda obsahuje extrémní množství dusičnanů nebo jiných škodlivin, popř. potřebujete průtok vyšší než 3 l/min, zvažte pořízení velkokapacitního filtru. Přestože má 6x až 18x větší objem hmot než klasická Dionela, vejde se pod kuchyňskou linku.
CHSKMn ukazuje na množství organických látek ve vodě. Chemie pitné vody nezná organické látky, které by byly lidskému zdraví prospěšné. Pitné vody nejlepší kvality mají CHSKMn menší než 1 mg/l. Toho docílíte kvalitním filtrem s aktivním uhlím.
Máte nízké pH vody, málo minerálů nebo chcete povýšit skvělou filtrovanou vodu na vodu téměř léčivou? Pak tedy filtrovanou vodu doporučujeme upravit kvalitním ionizátorem (ionizátory aQuator a Chanson), který zvyšuje pH a minerály jako je vápník, hořčík, sodík, draslík, zinek a další kladně nabité ionty. Alkalická voda má vysoké záporné hodnoty oxidačně redukčního potenciálu (ORP), zvyšuje koncentraci vodíkových molekul, proto má silné antioxidační účinky. Logicky zase snižuje obsah dusičnanů, dusitanů, chloridů, síranů, uhličitanů, fosforečnanů a dalších záporně nabitých iontů.